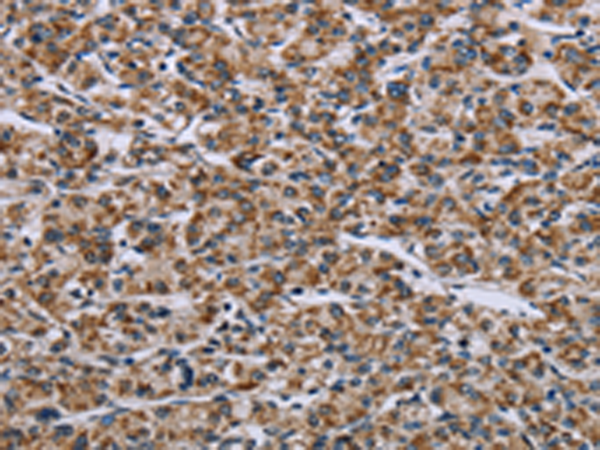
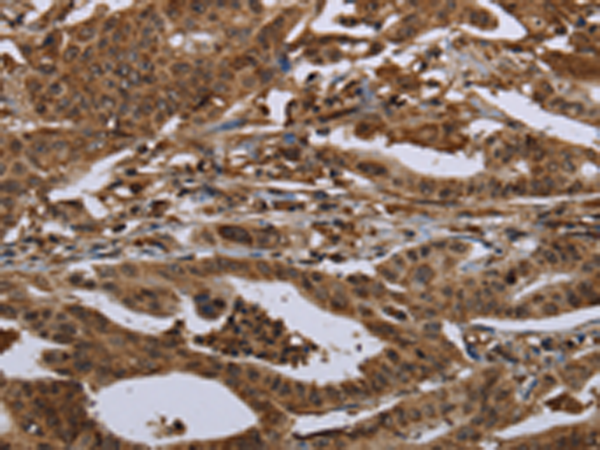

-
分类: 科研抗体货号: P08411别名: PRAP; SDR37C1应用: WB反应种属: Human, Mouse, Rat
-
分类: 科研抗体货号: P08394别名: HL; HTGL; LIPH; HDLCQ12应用: WB,IHC反应种属: Human, Mouse
-
分类: 科研抗体货号: P08410别名: KAR; SDR12C1应用: WB,IHC反应种属: Human, Mouse, Rat
-
分类: 科研抗体货号: P08393别名: CAS2; CASL; HEF1; CAS-L; CASS2应用: WB反应种属: Human
-
分类: 科研抗体货号: P08409别名: KE6; FABG; HKE6; FABGL; RING2; H2-KE6; SDR30C1; D6S2245E; dJ1033B10.9应用: WB,IHC反应种属: Human, Mouse, Rat
-
分类: 科研抗体货号: P08390别名: ObgH2; UG0751c10应用: IHC反应种属: Human
-
分类: 科研抗体货号: P08408别名: PL; CSA; CS-1; CSMT; hCS-1; hCS-A应用: WB,IHC反应种属: Human
-
分类: 科研抗体货号: P08421别名: DJ-2; DjA1; HDJ2; HSDJ; HSJ2; HSPF4; NEDD7; hDJ-2应用: WB,IHC反应种属: Human, Mouse, Rat
-
分类: 科研抗体货号: P08407别名: PGDH; PGDH1; PHOAR1; 15-PGDH; SDR36C1应用: IHC反应种属: Human, Mouse, Rat
-
分类: 科研抗体货号: P08420别名: HSDB; HSD3B; SDR11E2应用: IHC反应种属: Human

鄂公网安备42018502007531号
鄂公网安备42018502007531号

